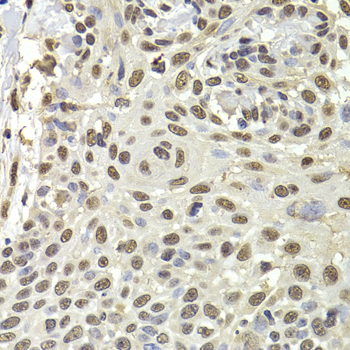
Immunohistochemistry - PUF60 Polyclonal Antibody

-
Product Name
PUF60 Polyclonal Antibody
- Documents
-
Description
Polyclonal antibody to PUF60
-
Tested applications
WB, IHC, IF, IP
-
Species reactivity
Human, Mouse, Rat
-
Alternative names
PUF60 antibody; FIR antibody; RoBPI antibody; SIAHBP1 antibody; VRJS antibody; poly binding splicing factor 60 antibody
-
Isotype
Rabbit IgG
-
Preparation
Antigen: Recombinant fusion protein containing a sequence corresponding to amino acids 243-542 of human PUF60 (NP_055096.2).
-
Clonality
Polyclonal
-
Formulation
PBS with 0.02% sodium azide, 50% glycerol, pH7.3.
-
Storage instructions
Store at -20℃. Avoid freeze / thaw cycles.
-
Applications
WB 1:500 - 1:2000
IHC 1:50 - 1:200
IF 1:50 - 1:100
IP 1:20 - 1:50 -
Validations

Western blot - PUF60 Polyclonal Antibody
Western blot analysis of extracts of various cell lines, using PUF60 antibody at 1:1000 dilution.Secondary antibody: HRP Goat Anti-Rabbit IgG (H+L) at 1:10000 dilution.Lysates/proteins: 25ug per lane.Blocking buffer: 3% nonfat dry milk in TBST.Detection: ECL Basic Kit .Exposure time: 30s.
Immunohistochemistry - PUF60 Polyclonal Antibody
Immunohistochemistry of paraffin-embedded human well-differentiated squamous skin carcinoma using PUF60 antibody at dilution of 1:100 (40x lens).

Immunofluorescence - PUF60 Polyclonal Antibody
Immunofluorescence analysis of HeLa cells using PUF60 antibody . Blue: DAPI for nuclear staining.

Immunoprecipitation - PUF60 Polyclonal Antibody
Immunoprecipitation analysis of 150ug extracts of A549 cells using 3ug PUF60 antibody . Western blot was performed from the immunoprecipitate using PUF60 antibody at a dilition of 1:500.
-
Background
DNA- and RNA-binding protein, involved in several nuclear processes such as pre-mRNA splicing, apoptosis and transcription regulation. In association with FUBP1 regulates MYC transcription at the P2 promoter through the core-TFIIH basal transcription factor. Acts as a transcriptional repressor through the core-TFIIH basal transcription factor. Represses FUBP1-induced transcriptional activation but not basal transcription. Decreases ERCC3 helicase activity. Does not repress TFIIH-mediated transcription in xeroderma pigmentosum complementation group B (XPB) cells. Is also involved in pre-mRNA splicing. Promotes splicing of an intron with weak 3'-splice site and pyrimidine tract in a cooperative manner with U2AF2. Involved in apoptosis induction when overexpressed in HeLa cells. Isoform 6 failed to repress MYC transcription and inhibited FIR-induced apoptosis in colorectal cancer. Isoform 6 may contribute to tumor progression by enabling increased MYC expression and greater resistance to apoptosis in tumors than in normal cells. Modulates alternative splicing of several mRNAs. Binds to relaxed DNA of active promoter regions. Binds to the pyrimidine tract and 3'-splice site regions of pre-mRNA; binding is enhanced in presence of U2AF2. Binds to Y5 RNA in association with TROVE2. Binds to poly(U) RNA.
Related Products / Services
Please note: All products are "FOR RESEARCH USE ONLY AND ARE NOT INTENDED FOR DIAGNOSTIC OR THERAPEUTIC USE"
